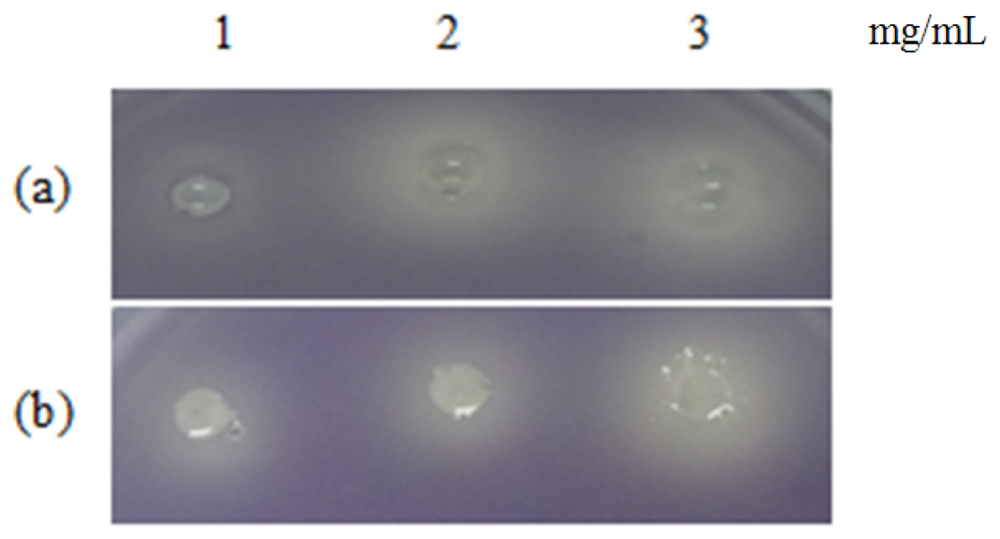
Sensors 13 03975f1 1024

Piper nigrum, Piper betle and Gnetum gnemon- Natural Food Sourcewith Anti-Quorum Sensing Properties
Abstract
: Various parts of Piper nigrum, Piper betle and Gnetum gnemon are used as food sources by Malaysians. The purpose of this study is to examine the anti-quorum sensing (anti-QS) properties of P. nigrum, P. betle and G. gnemon extracts. The hexane, chloroform and methanol extracts of these plants were assessed in bioassays involving Pseudomonas aeruginosa PA01, Escherichia coli [pSB401], E. coli [pSB1075] and Chromobacterium violaceum CV026. It was found that the extracts of these three plants have anti-QS ability. Interestingly, the hexane, chloroform and methanol extracts from P. betle showed the most potent anti-QS activity as judged by the bioassays. Since there is a variety of plants that serve as food sources in Malaysia that have yet to be tested for anti-QS activity, future work should focus on identification of these plants and isolation of the anti-QS compounds.1. Introduction
Quorum sensing (QS) is a widespread, well-known cell-to-cell communication phenomenon in proteobacteria. QS is used by proteobacteria for the regulation of behaviors such as bioluminescence, biofilm formation, antibiotic production, conjugation and virulence [1–3]. QS comprises of chemical communication among bacteria involving formation, secretion, detection and reaction to molecules known as autoinducers (AI). When the concentration of the AI in the population has reached a certain threshold level (which happens when bacteria cell density is high), the gene expression of the bacteria is altered as a respond to this event [1]. AIs or signaling molecules used by Gram-negative bacteria are known as N-acyl homoserine lactones (AHLs), while Gram-positive bacteria utilize post-translationally modified oligopeptides as signalling molecules [4].
Chromobacterium violaceum was first reported as a pathological strain when studies showed that this bacterium is the cause of infections in fetal water buffaloes in the Philippines [5]. C. violaceum is commonly found in soil and water, particularly in the tropical and subtropical areas and produces violacein, a purple pigmented compound when N-hexanoylhomoserine lactone (C6-HSL) is present [6,7]. C. violaceum CV026 is a mini-Tn5 mutant of C. violaceum which does not produce violacein unless it is supplied with C6-HSL. C. violaceum CV026 lacks the autoinducer synthase CviI and thus requires exogenous C6-HSL for violacein formation, which is QS-mediated [8].
On the other hand, Pseudomonas aeruginosa is an opportunistic pathogenic bacterium which is best known for its destructive effects in cystic fibrosis patients [9]. QS plays a major role in the regulation of P. aeruginosa virulence expression such as biofilm, pyocyanin, elastase, swarming and protease [10]. P. aeruginosa have two distinct yet hierarchal QS circuits, namely LasI-LasR and RhlI-RhlR. LasI, which is a LuxI homologue, produces 3-oxododecanoylhomoserine lactone (3-oxo-C12-HSL) that binds to LasR. Then, the LasR-autoinducer complex activates a range of genes including lasI, and a positive feedback loop from this interaction further activates the system [11,12].
Since it was known that the virulence phenotypes of bacteria can be quenched by blocking the QS, ongoing current research has been dedicated to the search for anti-QS compounds [13–23]. Anti-QS effects can be achieved by enzymatic approaches or using natural products [13]. Many quorum quenching bacteria producing AHL degradation enzymes have been isolated and studied [14–17]. Recent studies have demonstrated that QS antagonist compounds can be found in higher plants such as peas, vanilla, raspberry, Melicope lunu-ankenda, clove, and Myristica cinnamomea [18–23]. Our group has reported previously that malabaricone C isolated from the Myristica cinnamomea methanolic extract shows anti-QS activity that inhibits the virulence determinants of P. aeruginosa PAO1 [23]. In light of this finding, we have performed a systematic screening on edible plants in Malaysia in search of compounds with anti-QS properties.
Piper nigrum (common name: peppercorn) is a natural spice widely used in the Ayurvedic medicine. It is used in treatment for asthma, cough, diabetes and heart problems [24]. On the other hand, Piper betle (common name: betle leaves) was shown to contain compounds that have anti-diabetic and anti-allergic effects [25,26]. Gnetum gnemon (common name: belinjo leaves) fruits and leaves are consumed in Southeast Asians countries and the study conducted by Kato et al. [27] found that the seeds of G. gnemon have anti-oxidant properties.
In this study, we assessed the anti-QS properties of P. nigrum, P. betle and G. gnemon against P. aeruginosa PAO1, C. violaceum CV026 and Escherichia coli [pSB 401] and E. coli [pSB1075]. We found that the extracts of these plants possesses anti-QS properties and future studies should involve identification of the active compound(s) and the mechanism of action.
2. Experimental Section
2.1. Plant Sample Identification, Deposition of Voucher Specimens and Preparation of Plant Extracts
Plant samples were purchased from a local market in Selangor, Malaysia. Voucher specimens of P. nigrum (047695), P. betle (047696) and G. gnemon (047698) have been deposited in the Herbarium of University of Malaya. Samples were washed with sterile distilled water and finally rinse with 70% (v/v) ethanol before drying in the oven at 45 °C for three days. Dried samples were grounded to fine powder and soaked sequentially in hexane, chloroform and methanol. The extracts were then filtered through Whatman No. 1 filter paper. Removal of solvents from filtrate was done using a rotary evaporator (EYELA, Tokyo, Japan). Plant extract was dissolved in 100% DMSO (v/v) and were diluted using ultrapure water prior to be used.
2.2. Bacterial Strains, Growth Media and Culture Conditions
P. aeruginosa PA01 used in this study is from the lab collection while C. violaceum CV026 is a double mini-Tn5 mutant derived from ATCC 31532, KanR, HgR, cvil::Tn5 xylE, plus spontaneous StrR AHL biosensor [8]. On top of that, E. coli [pSB401] was constructed as a result from luxRluxl' (Photobacterium fischeri [ATCC7744])::luxCDABE (Photorhabdus luminescens [ATCC 29999]) fusion, pACYC184-derived, TetR, AHL biosensor while E. coli [pSB1075] was derived from lasRlasl' (P. aeruginosa PAO1)::luxCDABE (Photorhabdus luminescens [ATCC 29999]) fusion in pUC18 AmpR, AHL biosensor [28]. Unless otherwise stated, bacteria were routinely grown in Luria-Bertani (LB) medium (1% w/v NaCl, 1% w/v Tryptone, 0.5% w/v yeast extract) with shaking (220 rpm). C. violaceum CV026, were cultured in 28 °C, while P. aeruginosa strains at 37 °C. C. violaceum CV026 growth medium was supplemented with kanamycin (30 μg/mL) and chloramphenicol (30 μg/mL).
2.3. QS Inhibition against C. violaceum CV026
Briefly, 15 mL of overnight C. violaceum CV026 culture was added to 200 mL of molten LB agar that has been supplemented with C6-HSL(0.25 μg/mL). The C. violaceum CV026 agar suspension was poured into Petri dishes. Wells were made using sterile pipette tips once the agar solidified. Plant extract was placed in each well and DMSO (50% v/v) served as the negative control. The Petri dishes were incubated at 28 °C for 24 h. Halo formation on a purple background suggested that the plant extracts exhibited anti-QS. The violacein formed was quantified by incubating C. violaceum CV026 (supplemented with C6-HSL, 0.125 μg/mL) with plant crude extract in 96-well plate. The plate was incubated at 28 °C and after 16 h, the 96-well plate was completely dried at 60 °C. Then, DMSO (100 μL) was added onto each well and the 96-well plate was placed in the lab shaker [29]. The reading of the solubilized violacein was taken using a DYNEX MRX Elisa reader (Chantilly, VA, USA) at 590 nm.
2.4. Bioluminescence Assay of Biosensors E. coli [pSB 401] and E. coli [pSB 1075]
AHLs of 0.005 μg/mL [N-(3-oxohexanoyl)-L-homoserine lactone] and 0.0125 μg/mL [3-oxo-C12-HSL] were added respectively into overnight culture of E. coli [pSB401] and E. coli [pSB1075] biosensor cells to induce bioluminescence expression. Then, E. coli biosensor cells (230 μL) and plant extract (20 μL) were added into the well of a 96-well microtitre plate. The bioluminescence and OD495nm were determined every 30 min for 24 h using a Tecan luminometer (Infinite M200, Mannerdorf, Switzerland). Expression of bioluminescence was given as relative light unit (RLU)/OD495nm against time [30].
2.5. Anti-QS against P. aeruginosa PA01 Pyocyanin and Swarming
Overnight culture of P. aeruginosa PA01 was diluted to OD600 nm 0.2. Then, plant extract (250 μL) was added to P. aeruginosa PA01 (4.75 mL) and incubated at 37 °C for 24 h. The treated culture was extracted with chloroform (3 mL), followed by mixing the chloroform layer with 0.2 M HCl (1 mL). Absorbance of the extracted organic layer was measured using the UV-visible spectrophotometer (UV1601, Shidmazu, Kyoto, Japan) at 520 nm [31]. Swarming agar used in this study consists of glucose (1% w/v), Bacto agar (0.5% w/v), bactopeptone (0.5% w/v) and yeast extract (0.2% w/v). Briefly, solidified swarming agar (10 mL) was overlaid with swarming agar (4.75 mL) supplemented with plant extract (250 μL). Then, overnight culture of P. aeruginosa PA01 was inoculated onto the centre of the agar. The plate was incubated for 16 h at 37 °C [21].
2.6. Bacterial Growth
Bacterial growth was measured using methods by Hayouni and colleagues with modifications. Briefly, overnight cultures of P. aeruginosa PA01, C. violaceum CVO26, E. coli [pSB 401] and E. coli [pSB 1075] were diluted to OD600nm 0.001. Then, the bacteria and plant extracts were placed in a 96-well microtitre plate to make up a final volume of 250 μL in each well. The optical density OD600nm were determined every 30 min for 24 h by a Tecan luminometer (Infinite M200). Bacteria growth was determined by plotting the OD600nm against time [32].
2.7. Statistical Analysis
The significance differences between the mean values were tested using ANOVA test (P < 0.05) using GraphPad Prism software. All the assays were performed in triplicate.
3. Results and Discussion
P. nigrum, P. betle and G. gnemon used in this study had been used as food sources in the Southeast Asia region for centuries. These plants serve not only as foods, but they are also used as medicinal plants, although little is known about the anti-QS properties of these plants. This study provides a new insight on the anti-QS capabilities of these plant samples.
Table 1 shows the summary of the results obtained from this study. Violacein is a purple pigment produced by C. violaceum. It is a strong antioxidant and acts by protecting the bacteria membrane against oxidative stress [33]. Three extracts of P. nigrum and two extracts of P. betle (hexane and chloroform) causes halo formation on the purple background, indicating that these extracts have anti-QS properties against C. violaceum CV026. The formation of the halo zone around the well can be observed clearly in Figure 1. Plants extracts have been shown to exhibit anti-QS activity against C. violaceum CV026. For instance, Tremella fuciformis, vanilla, peas, black olive, bottle brush and graceful sandmat have shown their ability in inhibiting violacein production in previous study [20,34–36]. E. coli [pSB 401] and E. coli [pSB 1075] produces luminescence in the presence of short chain and long chain AHLs, respectively. Table 1, shows that all the plant samples interrupted response of E. coli [pSB 401] to short chain AHLs tested but only handful few samples acted against E. coli [pSB 1075]. This could suggest that the plant extracts may interrupt QS that depends on short chain AHLs but not long chain AHLs.
All three extracts of P. betle showed significant inhibition against pyocyanin formation by P. aeruginosa PA01. Quantified pyocyanin from hexane and chloroform extracts of P. betle (Figure 2) decreases with increasing plant extract concentration. Pyocyanin is a secondary metabolite produced by P. aeruginosa PA01. Pyocyanin can be found in large quantities in the sputum of cystic fibrosis patients and it disturbs ion transports, ciliary beatings and mucus secretion in the respiratory epithelial cells [37]. Swarming usually occurs on semi-solid agar and this motion enables the cell to colonize the surrounding surfaces [38]. The swarming agar that we had optimized in this study comprised of 0.5% (w/v) agar. Swarming inhibition against P. aeruginosa PA01 can be seen in swarming agar that has been seeded with P. betle (Methanol) extracts (Figure 3). Extend of inhibition increases as the concentration of plant extract increases. Pyocyanin formation and swarming motility are the virulent phenotypes that are regulated by QS. Compounds from P. betle were able to influence the synthesis of these virulent determinants and this makes P. betle extracts good candidate for further studies.
Growth of bacteria was monitored over the course of 24 h to make sure that the inhibitions caused by the plant extracts were solely due to anti-QS and not due to inhibition of bacterial growth. All of the extracts in Figure 4 showed significant inhibition against QS and results obtained after 24 h showed that the plant extracts only have anti-QS properties and did not cause any form of inhibition in the bacterial growth. Same observation was obtained from other plant extracts when cultured together with other bacterial strains. DMSO of final concentration of 0.08%, 0.16% and 0.24% serves as the negative controls at each corresponding concentration.
Consequently, the results obtained from this study also showed that the extracts of P. betle have the most effective inhibition against QS as compared to P. nigrum and G. gnemon. We cannot be sure at which level QS has been modulated by these extracts because the extracts could be competing or disrupting the AHLs binding to the receptors by degradation of AHLs; blocking AHLs from forming AHL-receptor complex; changing the structures of the enzymes that is involved AHLs synthesis. Tertiary plants have developed some form of protective mechanism against bacterial infections through evolution. It is proven through studies which found that chestnut honey, Terminalia catappa, Chinese medicinal plants, Scorzonera sandrasica and Italian medicinal plants possess anti-QS activity [39–43]. Since they are food sources, the compounds derived will have lower possibility of causing any unwanted reaction in the human system. The samples used in this study can be widely found in Malaysia. Our future goal is to screen for more plants in Malaysia that possess anti-QS.
4. Conclusions
Usage of antibiotics has caused pathogenic bacteria to become resistant and poses a global threat to public health. QS provides an alternative solution because by targeting bacterial communication the expression of the virulence phenotype is inhibited. Our data illustrated that these plants possess compounds that can be used to quench QS-mediated virulence determinants. Currently, we are in the process of isolating these compounds using column chromatography and preparative HPLC, and molecular structures will then be determined by mass spectrometry and NMR spectroscopy.
Acknowledgments
The author (Kok-Gan Chan) thanks the University of Malaya for the High Impact Research Grant funding (HIR/MOHE grant no. A000001-50001), and Li Ying Tan thanks Yayasan Khazanah for M.Sc. Scholarship.
References
- Waters, C.M.; Bassler, B.L. Quorum sensing: Cell-to-cell communication in bacteria. Annu. Rev. Cell Dev. Biol. 2005, 21, 319–346. [Google Scholar]
- Reading, N.C.; Sperandio, V. Quorum sensing: The many languages of bacteria. FEMS Microbiol. Lett. 2006, 254, 1–11. [Google Scholar]
- Taga, M.E. Bacterial signal destruction. ACS Chem. Biol. 2007, 2, 89–92. [Google Scholar]
- Bassler, B.L. How bacteria talk to each other: Regulation of gene expression by quorum sensing. Curr. Opin. Microbiol. 1999, 2, 582–587. [Google Scholar]
- Duran, N.; Menck, C.F.M. Chromobacterium violaceum: A review of pharmacological and industrial perspectives. Crit. Rev. Microbiol. 2001, 27, 201–222. [Google Scholar]
- Teoh, A.Y.B.; Hui, M.; Ngo, K.Y.; Wong, J.; Lee, K.F.; Lai, P.B.S. Fatal septicaemia from Chromobacterium violaceum: Case reports and review of the literature. Hong Kong Med. J. 2006, 12, 228–231. [Google Scholar]
- Blosser, R.S.; Gray, K.M. Extraction of violacein from Chromobacterium violaceum provides a new quantitative bioassay for N-acyl homoserine lactone autoinducers. J. Microbiol. Methods. 2000, 40, 47–55. [Google Scholar]
- McClean, K.H.; Winson, M.K.; Fish, L.; Taylor, A.; Chhabra, S.R.; Camara, M.; Daykin, M.; Lamb, J.H.; Swift, S.; Bycroft, B.W.; et al. Quorum sensing and Chromobacterium violaceum: Exploitation of violacein production and inhibition for the detection of N-acylhomoserine lactones. Microbiology 1997, 143, 3703–3711. [Google Scholar]
- Eberl, L.; Tummler, B. Pseudomonas aeruginosa and Burkholderia cepacia in cystic fibrosis: Genome evolution, interactions and adaptation. Int. J. Med. Microbiol. 2004, 294, 123–131. [Google Scholar]
- Smith, R.S.; Iglewski, B.H.P. aeruginosa quorum-sensing systems and virulence. Curr. Opin. Microbiol. 2003, 6, 56–60. [Google Scholar]
- Whitehead, N.A.; Barnard, A.M.L.; Slater, H.; Simpson, N.J.L.; Salmond, G.P.C. Quorum-sensing in gram-negative bacteria. FEMS Microbiol. Rev. 2001, 25, 365–404. [Google Scholar]
- Storey, D.G.; Ujack, E.E.; Rabin, H.R.; Mitchell, I. Pseudomonas aeruginosa lasR transcription correlates with the transcription of lasA, lasB, and toxA in chronic lung infections associated with cystic fibrosis. Infect. Immun. 1998, 66, 2521–2528. [Google Scholar]
- Hong, K.W.; Koh, C.L.; Sam, C.K.; Yin, W.F.; Chan, K.G. Quorum quenching revisited- from signal decays to signaling confusion sensors. Sensors 2012, 12, 4661–4696. [Google Scholar]
- Wong, C.S.; Yin, W.F.; Sam, C.K.; Koh, C.L.; Chan, K.G. Characterisation of wetland quorum quenching Pseudomonas aeruginosa strain 2SW8 and its 2-heptyl-3-hydroxy-4-quinolone production. New Microbiol. 2012, 35, 43–51. [Google Scholar]
- Chong, T.M.; Koh, C.L.; Sam, C.K.; Choo, Y.M.; Yin, W.F.; Chan, K.G. Characterization of quorum sensing and quorum quenching soil bacteria isolated from Malaysian tropical montane forest. Sensors 2012, 12, 4846–4859. [Google Scholar]
- Wong, C.S.; Yin, W.F.; Choo, Y.M.; Sam, C.K.; Koh, C.L.; Chan, K.G. Coexistence of quorum-quenching and quorum-sensing in tropical marine Pseudomonas aeruginosa strain MW3A. World J. Microbiol. Biotechnol. 2012, 28, 453–461. [Google Scholar]
- Yin, W.F.; Tung, H.J.; Sam, C.K.; Koh, C.L.; Chan, K.G. Quorum quenching Bacillus sonorensis isolated from soya sauce fermentation brine. Sensors 2012, 12, 4065–4073. [Google Scholar]
- Choo, J.H.; Rukayadi, Y.; Hwang, J.-K. Inhibition of bacterial quorum sensing by vanilla extract. Lett. Appl. Microbiol. 2006, 42, 637–641. [Google Scholar]
- Vatte, D.A.; Mihalik, K.; Crixell, S.H.; McLean, R.J.C. Dietary phytochemicals as quorum sensing inhibitors. Fitoterapia 2007, 78, 302–310. [Google Scholar]
- Bauer, W.D.; Teplitski, M. Can plants manipulate bacterial quorum sensing? Aust. J. Plant Physiol. 2001, 28, 913–921. [Google Scholar]
- Tan, L.Y.; Yin, W.F.; Chan, K.G. Silencing quorum sensing through extracts of Melicope lunu-ankenda. Sensors 2012, 12, 4339–4351. [Google Scholar]
- Krishnan, T.; Yin, W.F.; Chan, K.G. Inhibition of quorum sensing-controlled virulence factor production in Pseudomonas aeruginosa PA01 by Ayurveda spice clove (Syzgium aromaticum) bud extract. Sensors 2012, 12, 4016–4030. [Google Scholar]
- Chong, Y.M.; Yin, W.F.; Ho, C.Y.; Mustafa, M.R.; Hadi, A.H.A.; Awang, K.; Narrima, P.; Koh, C.L.; Appleton, D.R.; Chan, K.G. Malabaricone C from Myristica cinnamomea exhibits anti quorum sensing activity. J. Nat. Prod. 2011, 74, 2261–2261. [Google Scholar]
- Rao, M.R.; Rajeswara Rao, B.R. Medicinal Plants in Tropical Homegardens. In Tropical Homegardens, 1st ed.; Kumar, B.M., Nair, P.K.R., Eds.; Springer Netherlands: Dordrecht, The Netherlands, 2006; Volume 3, pp. 205–232. [Google Scholar]
- Arambewela, L.S.R.; Arawwawala, L.D.A.M.; Ratnasooriya, W.D. Antidiabetic activities of aqueous and ethanolic extracts of Piper betle leaves in rats. J. Ethnopharmocol. 2005, 102, 239–245. [Google Scholar]
- Mali, W.; Naoki, I.; Hiroyuki, T.; Witchuda, T.; Hirochi, N. Inhibitory effects of Piper betle on production of allergic mediators by bone marrow-derived mast cells and lung epithelial cells. Int. Immunopharmacol. 2008, 8, 453–457. [Google Scholar]
- Eishin, K.; Yuji, T.; Fujio, S. Stilbenoids isolated from the seeds of Melinjo (Gnetum gnemon L.) and their biological activity. J. Agric. Food Chem. 2009, 57, 2544–2549. [Google Scholar]
- Winson, M.K.; Swift, S.; Fish, L.; Throup, J.P.; Jorgensen, F.; Chhabra, S.R.; Bycroft, B.W.; Williams, P.; Stewart, G.S. Construction and analysis of luxCDABE-based plasmid sensors for investigating N-acyl homoserine lactone-mediated quorum sensing. FEMS Microbiol. Lett. 1998, 163, 185–192. [Google Scholar]
- Martinelli, D.; Grossmann, G.; Sequin, U.; Brandl, H.; Bachofen, R. Effects of natural and chemically synthesized furanones on quorum sensing in Chromobacterium violaceum. BMC Microbiol. 2004, 4, 25. [Google Scholar]
- Winzer, K.; Falconer, C.; Garber, N.C.; Diggle, S.P.; Camara, M.; Williams, P. The Pseudomonas aeruginosa lectins PA-IL and PA-IIL are controlled by quorum sensing and by RpoS. J. Bacteriol. 2000, 182, 6401–6411. [Google Scholar]
- Essar, D.W.; Eberly, L.; Hadero, A.; Crawford, I. Identification and characterization of genes for a second anthranilate synthase in Pseudomonas aeruginosa: Interchangeability of the two anthranilate synthases and evolutionary implications. J. Bacteriol. 1990, 172, 884–900. [Google Scholar]
- Hayouni, E.A.; Bouix, M.; Abedrabba, M.; Leveau, J.-Y.; Hamdi, M. Mechanism of action of Melalueca armillaris (sol. ex gaertu) sm. essential oil on six lab strains as assessed by multiparametric flow cytometry and automated microtiter-based assay. Food Chem. 2008, 111, 707–718. [Google Scholar]
- Konzen, M.; Marco, D.D.; Cordova, C.A.S.; Vieira, T.O.; Antonio, R.G.; Creczynski-Pasa, T.B. Antioxidant properties of violacein: Possible relation on its biological function. Bioorg. Med. Chem. 2006, 14, 8307–8313. [Google Scholar]
- Teplitski, M.; Robinson, J.B.; Bauer, W.D. Plants secrete substances that mimic bacterial N-acyl homoserine lactone signal activities and affect population density-dependent behaviors in associated bacteria. Mol. Plant Microbe Interact. 2000, 13, 637–648. [Google Scholar]
- Zhu, H.; Sun, S.J. Inhibition of bacterial quorum sensing-regulated behaviors by Tremella fuciformis extract. Curr. Microbiol. 2008, 57, 418–422. [Google Scholar]
- Adonizio, A.L.; Downum, K.; Bennett, B.C.; Mathee, K. Anti-quorum sensing activity of medicinal plants in southern Florida. J. Ethnopharmacol. 2006, 105, 427–435. [Google Scholar]
- Gerene, M.D.; Michelle, A.R.; George, T.R.; Charles, D.C.; Bradley, E.B. Psedomonas pyocyanin alters calcium signaling in human airway epithelial cells. AJP Lung Physiol. 1998, 274, 893–900. [Google Scholar]
- Rasmussen, T.B.; Manefield, M.; Andersen, J.B.; Eberl, L.; Uffe, A.; Carsten, C.; Peter, S.; Staffan, K.; Michael, G. How Delisea pulchra furanones affect quorum sensing and swarming motility in Serratia liquefaciens MG1. Microbiology 2000, 146, 3237–3244. [Google Scholar]
- Pilar, T.; Angel, G.-I.; Francisco, T.-B.; Ana, A. Inhibition by chestnut honey of N-acyl-L-homoserine lactones and biofilm formation in Erwinia carotovora, Yersinia enterocolitica, and Aeromonas hydrophila. J. Agric. Food Chem. 2009, 57, 11186–11193. [Google Scholar]
- Joemar, C.T.; Jusal, P.Q.; Rose, M.G.P.; Evangline, C.A.; Windell, L.R. Tannin-rich fraction from Terminalia catappa inhibits quorum sensing (QS) in Chromobacterium violaceum and the QS-controlled biofilm maturation and LasA staphylolytic activity in Pseudomonas aeruginosa. J. Ethnopharmacol. 2011, 134, 865–871. [Google Scholar]
- Khee, H.K.; Foong-Yee, T. Screening of traditional chinese medicinal plants for quorum-sensing inhibitors activity. J. Microbiol. Immunol. Infect. 2011, 44, 144–148. [Google Scholar]
- Gulgun, B.-T.; Seyhan, U.; Aysel, U.; Ozgur, C. Inhibition of quorum sensing-regulated behaviors by Scorzonera sandrasica. Curr. Microbiol. 2007, 55, 114–118. [Google Scholar]
- Quave, C.I.; Plano, L.R.W.; Pantuso, T.; Bennett, B.C. Effects of extracts from Italian medicinal plants on planktonic growth, biofilm formation and adherence of methicillin-resistant Staphylococcus aureus. J. Ethnopharmacol. 2008, 118, 418–428. [Google Scholar]

| Plant samples (solvent extract) | Violacein Quantification Assay | C. violaceumPlate Assay | E. coli [pSB 401] | E. coli [pSB1075] | Pyocyanin Assay | Swarming Assay |
|---|---|---|---|---|---|---|
| P. nigrum (hexane) | √ | √ | √ | - | - | - |
| P. nigrum (chloroform) | √ | √ | √ | - | - | - |
| P. nigrum (methanol) | √ | √ | √ | - | - | - |
| P. betle (hexane) | √ | √ | √ | √ | √ | - |
| P. betle (chloroform) | √ | √ | √ | - | √ | - |
| P. betle (methanol) | √ | - | √ | - | √ | √ |
| G. gnemon (hexane) | - | - | √ | - | - | - |
| G. gnemon (chloroform) | - | - | √ | √ | √ | - |
| G. gnemon (methanol) | - | - | √ | √ | - | - |
© 2013 by the authors; licensee MDPI, Basel, Switzerland. This article is an open access article distributed under the terms and conditions of the Creative Commons Attribution license (http://creativecommons.org/licenses/by/3.0/).
Share and Cite
Tan, L.Y.; Yin, W.-F.; Chan, K.-G. Piper nigrum, Piper betle and Gnetum gnemon- Natural Food Sourcewith Anti-Quorum Sensing Properties. Sensors 2013, 13, 3975-3985. https://doi.org/10.3390/s130303975
Tan LY, Yin W-F, Chan K-G. Piper nigrum, Piper betle and Gnetum gnemon- Natural Food Sourcewith Anti-Quorum Sensing Properties. Sensors. 2013; 13(3):3975-3985. https://doi.org/10.3390/s130303975
Chicago/Turabian StyleTan, Li Ying, Wai-Fong Yin, and Kok-Gan Chan. 2013. "Piper nigrum, Piper betle and Gnetum gnemon- Natural Food Sourcewith Anti-Quorum Sensing Properties" Sensors 13, no. 3: 3975-3985. https://doi.org/10.3390/s130303975






